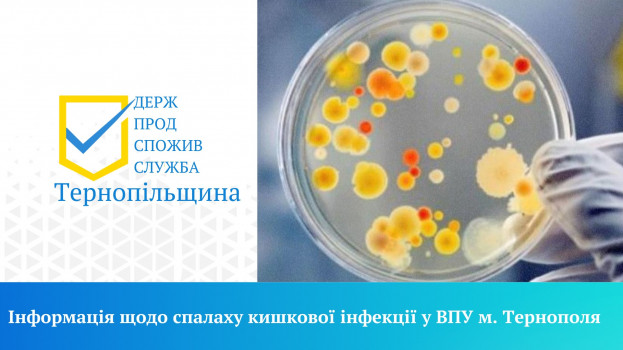

Спеціалісти Тернопільського районного управління Головного управління Держпродспоживслужби в Тернопільській області повідомили, що завершили розслідування причин та умов виникнення спалаху гострої кишкової інфекції серед учнів Тернопільського вищого професійного училища сфери послуг і туризму.
У ході проведеного розслідування визначено межі вогнища, проведено оцінку даних епіданамнезу, організовано першочергові заходи щодо припинення дії ймовірних факторів передачі інфекції, відібрано матеріал для лабораторного дослідження (20 змивів з об’єктів навколишнього середовища в гуртожитку та на харчоблоці закладу, 2 взірці води питної з центральної мережі та 1 взірець води з колонки-качалки, що знаходиться поблизу гуртожитку).
За результатами лабораторних досліджень безпечності та якості питної води із вказаної колонки-качалки, проведених фахівцями Тернопільської регіональної державної лабораторії Держпродспоживслужби, встановлено невідповідність зазначеного взірця питної води вимогам ДСанПіН 2.2.4-171-10 «Гігієнічні вимоги до води питної, призначеної для споживання людиною» за мікробіологічними показниками.
З метою забезпечення санітарно – епідемічного благополуччя населення та реалізації заходів, спрямованих на профілактику та зниження рівня інфекційної захворюваності, отримані дані лабораторних досліджень води доведено до відома керівництва КП «Тернопільводоканал» та надано рекомендації щодо проведення термінового комплексу заходів стосовно приведення води питної у колонці-качалці за адресою: м. Тернопіль, вул. Острозького, 45 у відповідність до нормативних мікробіологічних показників (виявлення та усунення джерела ймовірного забруднення, при необхідності проведення дезінфекції, додаткової «прокачки» води у колонці-качалці тощо).
Також проведено позаплановий захід державного нагляду (контролю) у сфері безпечності харчових продуктів – перевірку закладу громадського харчування кафе «LOFT» в м. Тернополі, звідки замовляли доставку суші та піц у гуртожиток. Для дослідження за мікробіологічними показниками була відібрана сировина, відхилень не виявлено.
Станом на 02.05.2023 р. повторних випадків захворювань більше не зареєстровано, вогнище локалізовано.
Причиною спалаху стали продукти харчування та страви, що були привезені з дому та були вжиті після закінчення терміну їх придатності; зараженню сприяло і недотримання правил особистої гігієни учнями в умовах проживання у гуртожитку.
Джерело: ПЕРШИЙ онлайн



